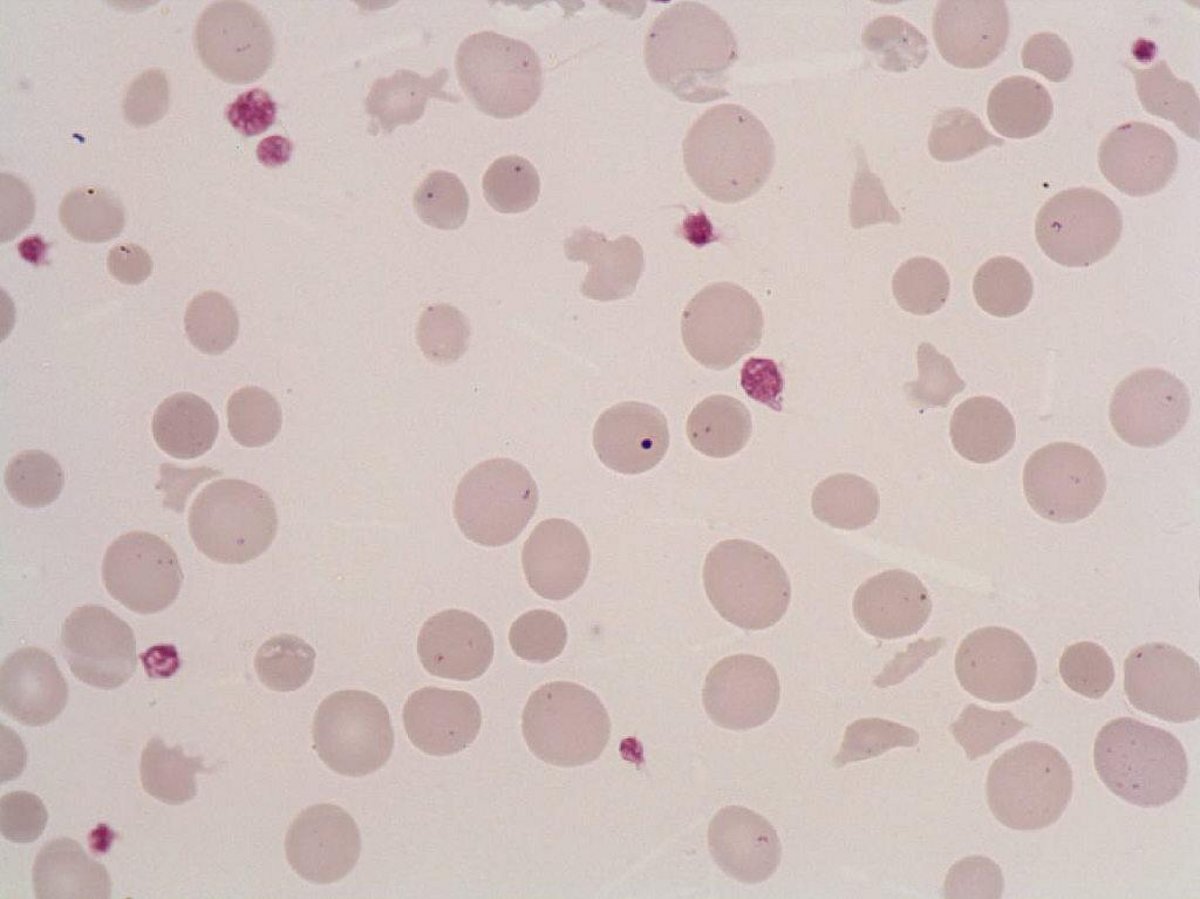
Howell-Jolly_bodies

Howell-Jolly bodies
- Size : 1 µm
- Normal values :
- Description / Pathology :
Dark purple intra-erythrocytic corpuscle (MGG staining) of spherical shape.
Hereditary diseases (congenital asplenia). Acquired pathologies (splenectomy, functional asplenia).
Dark purple intra-erythrocytic corpuscle (MGG staining) of spherical shape.
Hereditary diseases (congenital asplenia). Acquired pathologies (splenectomy, functional asplenia).